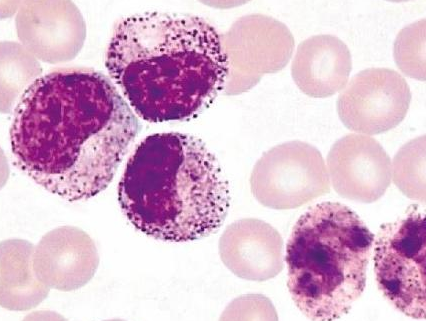

【资讯导读】威托克的商品名是VENclexta,通用名是Venetoclax(VEN),维奈托斯、维尼托克的不同名称是GDC-0199、ABT-199、GDC0199和RG7601,英文缩写为Ven。威尼克用于治疗慢性淋巴细胞白血病(CLL)、小淋巴细
威托克的商品名是VENclexta,通用名是Venetoclax(VEN),维奈托斯、维尼托克的不同名称是GDC-0199、ABT-199、GDC0199和RG7601,英文缩写为Ven。威尼克用于治疗慢性淋巴细胞白血病(CLL)、小淋巴细胞淋巴瘤(SLL)和急性髓细胞白血病(AML)。
威托克是美国艾伯维公司和瑞士罗氏集团(RocheGroup)开发的第一种靶向B细胞淋巴瘤因子2(BCL-2)的选择性抑制剂。2015年1月16日,它被美国食品和药物管理局授予突破性药物和优先审查的地位。通过加快审批程序,于2016年4月11日获准上市。适用于治疗慢性淋巴细胞白血病和难治性或复发性17p突变基因缺失的患者。
关于威托克的安全性分析。在49名患者中,42名(86%)得到有效治疗,其中25名(51%)获得完全缓解(骨髓缓解与否)。病人可以对所有目标剂量的静脉注射产生反应。首次应答的中位时间为2.9个月。中位时间为9.2个月后观察到完全缓解。
在完成联合治疗后,患者接受了威托克单药治疗。中位数7个月后,11名患者获得完全缓解,14名患者获得完全缓解,骨髓缓解与否。在42名有效患者中,67%(28/42)未发现微小残留病变。根据数据分析,82%的患者没有疾病进展,中位进展时间少于2年,89%的患者仍有反应。
研究人员表示,以前的研究表明,威托克单药治疗的完全缓解率接近20%,而这种新的联合方案的完全缓解率为51%,与微小残留病变相关的数据是前所未有的。此外,11名患者出现疾病进展,其中6名获得部分缓解。
威托克药品详细信息请进入:https://www.inmedf.com/zhongliu/bxb/20201419.html